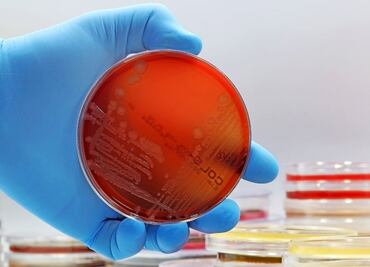
Prevención de infección por salmonella en época de calor

Gracias a la alianza entre la Fundación Grupo México y Cemex, del 10 al 14 de junio en Huichapan y del 17 al 21 de junio en Apan, 500 hidalguenses recibirán atención médica integral y gratuita.
09 / noviembre / 2025 | 13:41 hrs.

Gracias a la alianza entre la Fundación Grupo México y Cemex, del 10 al 14 de junio en Huichapan y del 17 al 21 de junio en Apan, 500 hidalguenses recibirán atención médica integral y gratuita.

Laboran en siete hospitales que ahora forman parte del esquema IMSS-Bienestar.

Serán 700 comités de clínicas a quienes se les entregará el recurso.

¡Cuidemos nuestra salud y el medio ambiente!

Durante el 2023, la Secretaría de Salud federal registró 10 fallecimientos maternos.

La entidad se une a la lucha global para reducir el consumo de tabaco y proteger la salud de sus jóvenes, promoviendo un futuro más saludable y libre de humo.

Buscan cubrir especialidades de cirugía, cuidados intensivos, neonatales y de pediatría.
Sigue estas recomendaciones de la Secretaría de Salud de Hidalgo para protegerte.

Pacientes accidentados graves no fueron recibidos en IMSS y Hospital Regional.

La Secretaría de Salud reconoce la grave amenaza del consumo de fentanilo y está comprometida a proteger la salud de los hidalguenses.